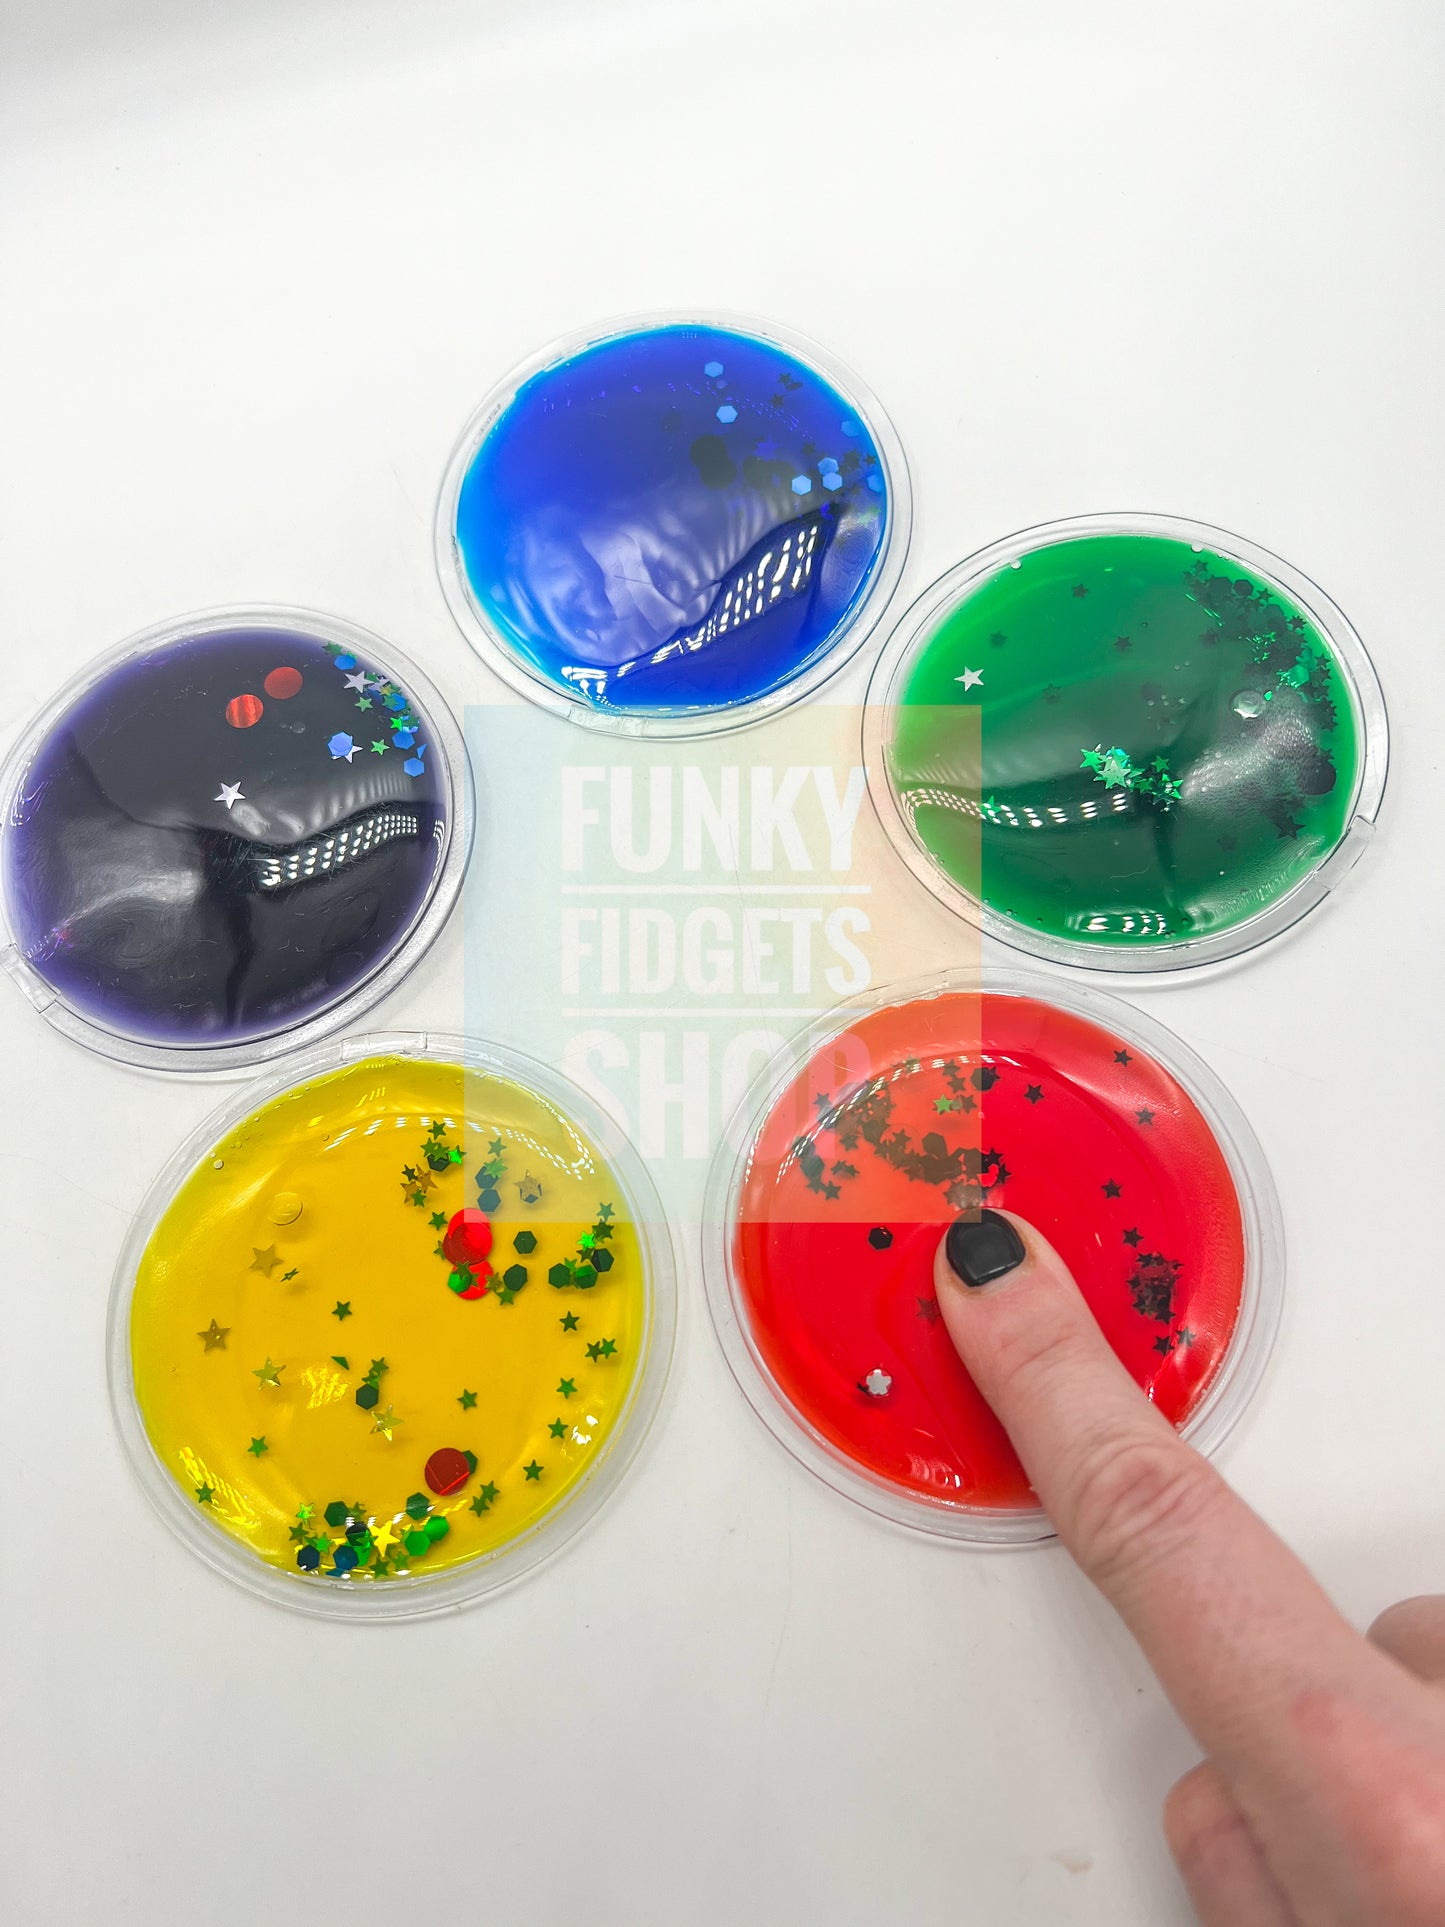
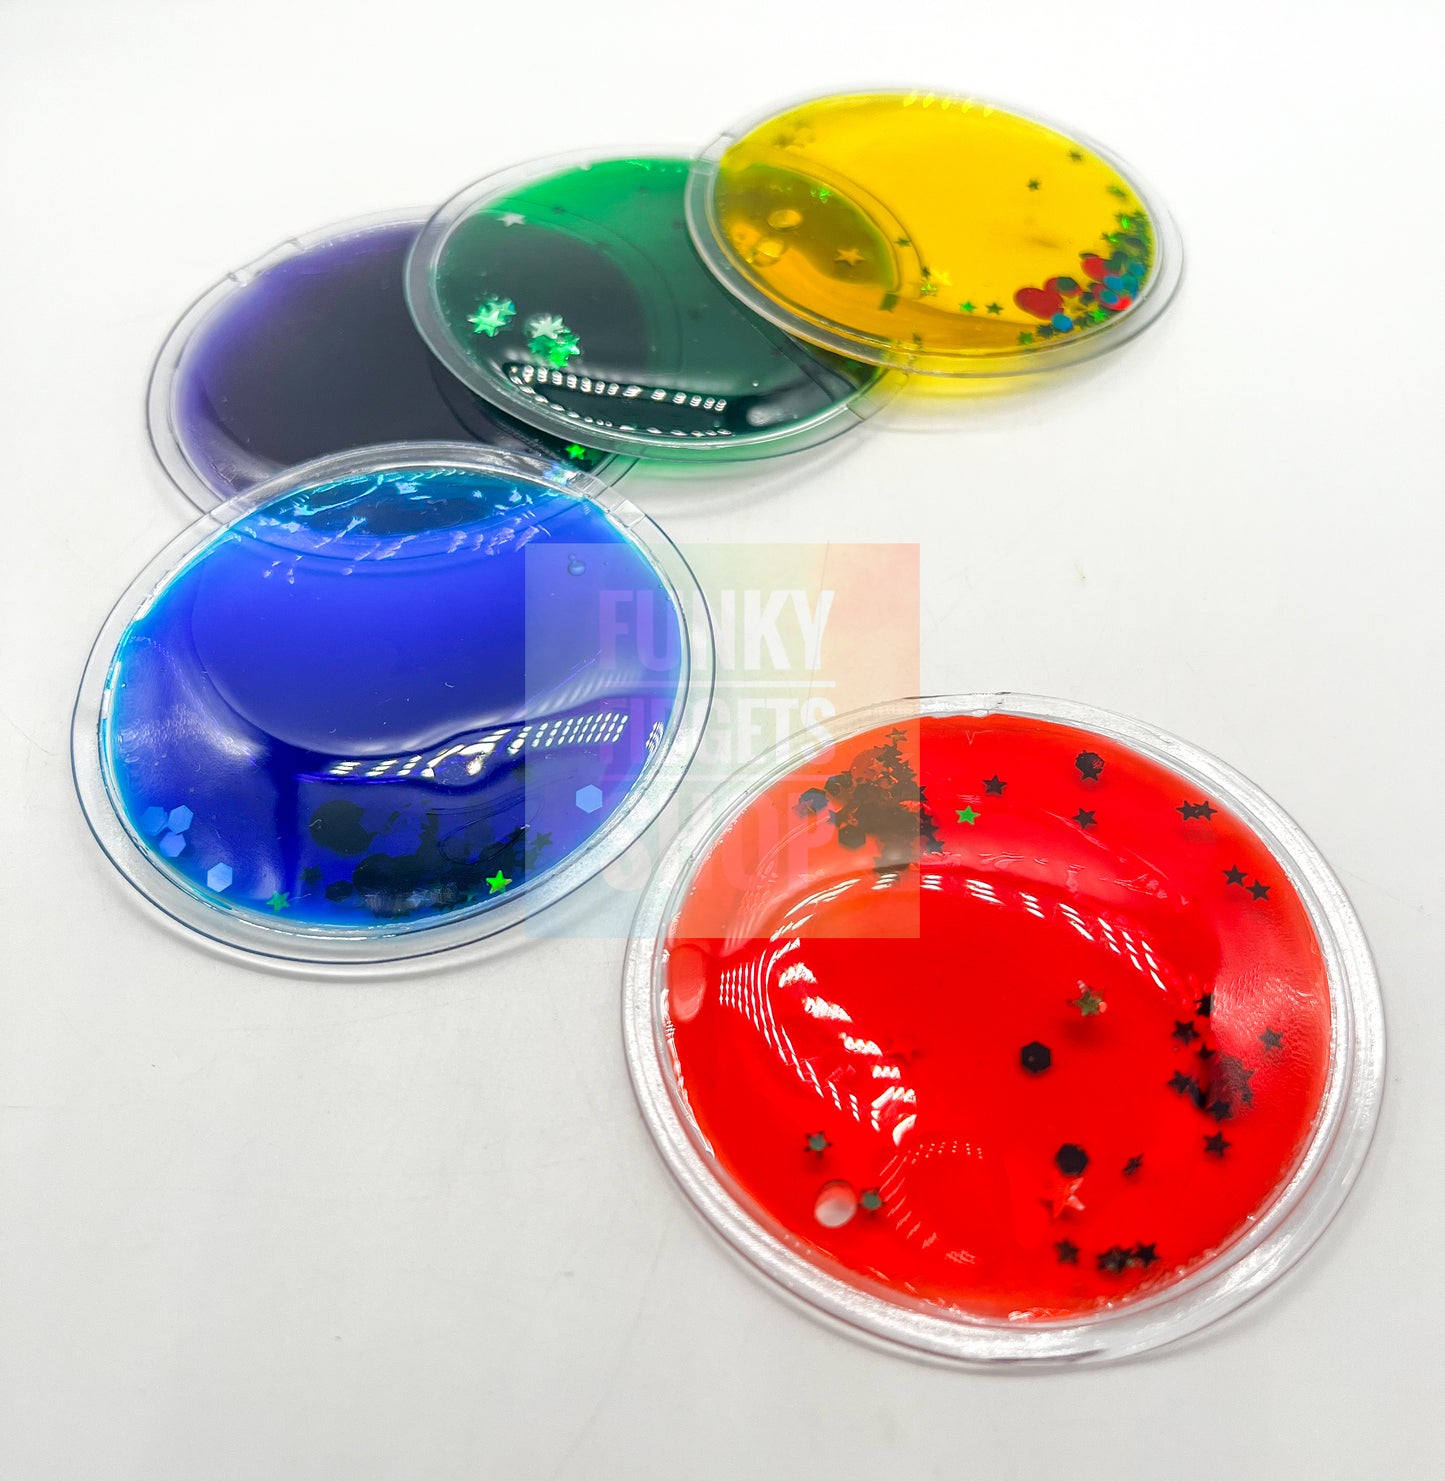

Squishy Sensory circle
FunkyFidgetsShop
Couldn't load pickup availability
These squidgy circles are highly tactile and visually stimulating, made from vac-formed plastic and filled with sparkling liquid. These glittery gel shapes can be squeezed, bent and pressed. Great sensory tool for autism. Children and adults alike will enjoy experiencing these tactile, colourful, glittery, sparkly Colour Shapes, while introducing colours at the same time. Try experiencing them as a stencil, on a washing line, great to hide in sand, water, snow etc or as a visual aid.
Select your colour.
approx size 5cm
WARNING(S):
- Not suitable for children under 3 years old.
- Only for domestic use.
- To be used under the direct supervision of an adult.
- Liquid filled objects are delicate so please handle with care.
DISPATCH TIME:
We aim to dispatch items within 1-3 days of purchase. Postage times depend on your country, please visit the ‘Shipping’ page for further details